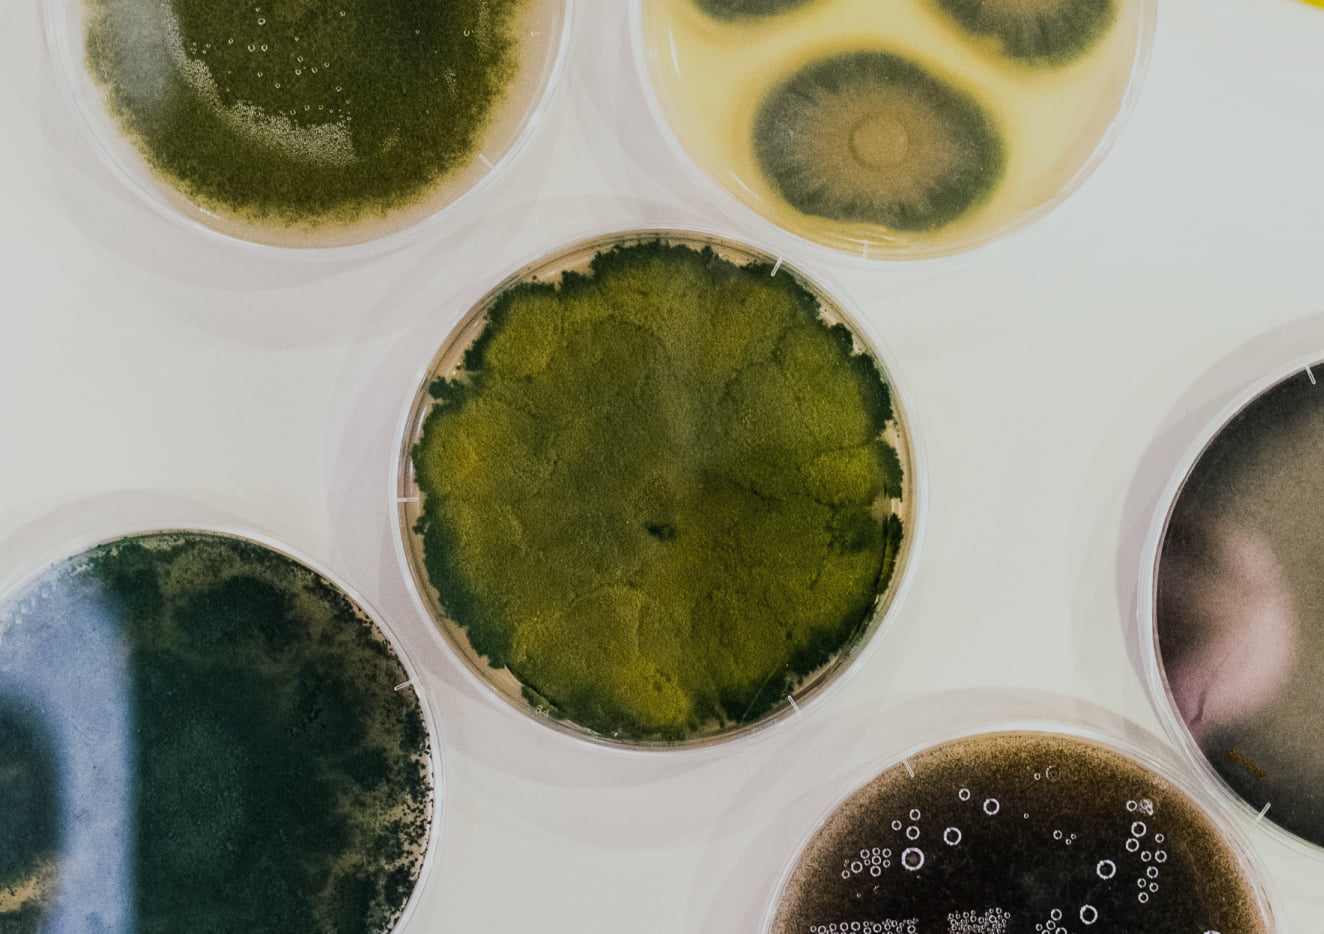

Nuestros Productos
Descubre nuestras mezclas funcionales de herbolaria y adaptógenos, formuladas por expertos con más de 20 años de experiencia. Diseñadas para acompañarte en tu día a día, nuestras fórmulas promueven el equilibrio y el bienestar integral.
Resource | Digestión y energía
Precio de oferta$ 720.00
Relajación y Descanso Bundle
Precio de oferta$ 1,150.00
¿Qué distingue al Essential Kit?
Nuestros Ingredientes
Nuestra propuesta de valor radica en ofrecerte rituales de bienestar probados y funcionales que se integran fácilmente en tu rutina diaria.


Estoy durmiendo mucho más profundo, y el spray me ayuda a manejar el estrés y mejorar mi ánimo.
Desde que tomo el té, duermo delicioso y me siento mucho mejor del estómago. Los productos de Sencia me han ayudado a descansar bien y a tener más energía en el gimnasio.
Sé parte de nuestra historia
Encuéntranos en Instagram como @sencianaturals.